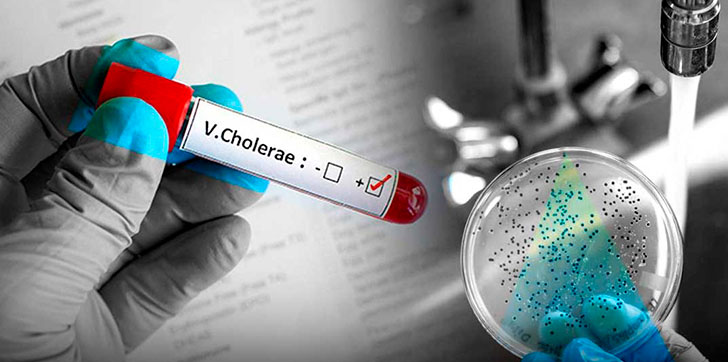

Aumentan a dos los casos de cólera en Barahona importados de Haití
AGENDA56, SANTO DOMINGO.- El Ministerio de Salud Pública confirmó este miércoles un nuevo caso importado de cólera en Enriquillo, en la provincia Barahona, lo que aumenta a dos los contagios en esa localidad del suroeste del país.
Este nuevo caso corresponde a una mujer de 48 años, de nacionalidad haitiana, y que llegó recientemente de su país, al igual que otra mujer de 25 años, que dio positivo a la enfermedad el fin de semana.
Las otras personas que presentaron un cuadro de diarrea aguda en esa localidad, fueron medicadas y en la mayoría despachadas a sus casas tras estar ingresados en los hospitales Jaime Mota y el hospital de Enriquillo, en Barahona, dijo la directora del departamento de Gestión de Riesgos y Desastres de Salud, Gina Estrella, citada hoy en un comunicado por Salud Pública.
El brote diarreico fue causado por el uso de agua contaminada no apta para consumo.
En ese sentido, el Ministerio de Salud informó de que, a través de la Dirección Provincial de Salud, continúa con el cerco epidemiológico y la intervención permanente en la zona, para detectar, prevenir e investigar cualquier otro caso sospechoso de la enfermedad.
Desde que en la República Dominicana se detectara el primer paciente de cólera en octubre pasado, los casos confirmados superan el centenar.
Ese primer caso correspondió a una mujer de 32 años y nacionalidad haitiana que acababa de regresar del vecino país, donde la reaparición de la enfermedad ha causado ya unas 750 muertes. EFE





